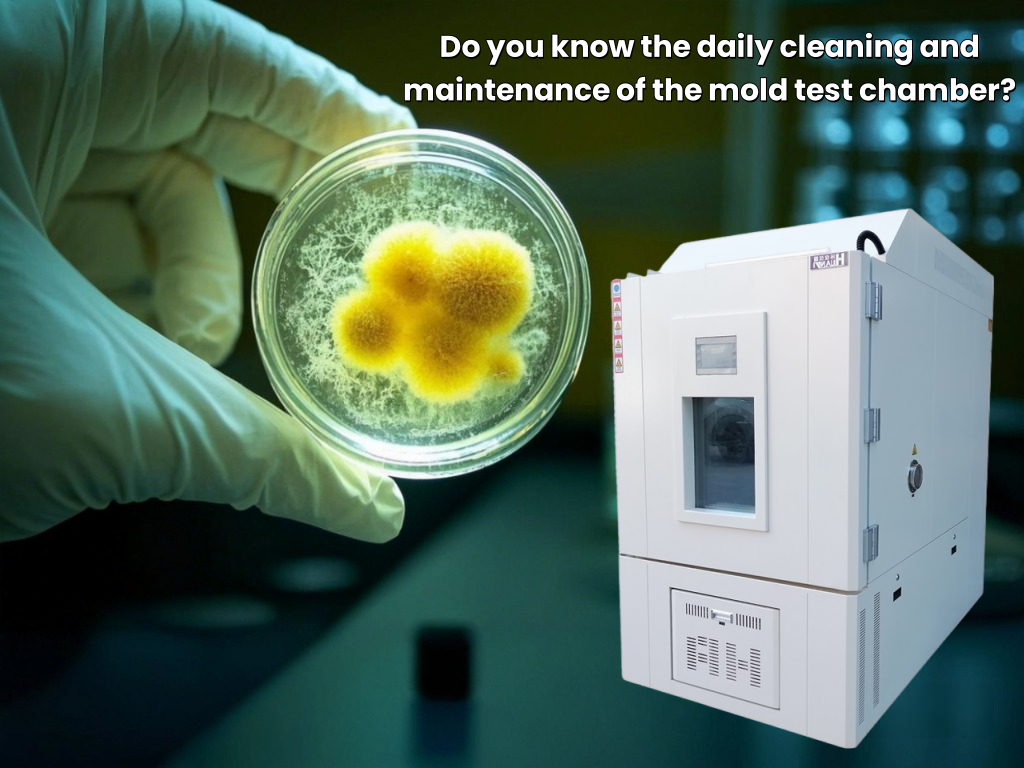
Daily cleaning and maintenance of mold test chamber

Trump's Tariff Increase Policy May Impact the Global Test Chamber Industry
US President Trump announced at the White House that he would impose so-called "reciprocal tariffs" on trading partners. This statement caused a shock in the global trade market. As an important part of the high-tech manufacturing industry, the test chamber industry may face a new round of cost increases and supply chain adjustment pressure.

Constant Temperature and Humidity Test Chamber: Guardian of the Agricultural Pesticide Field
With the acceleration of agricultural modernization, Constant Temperature And Humidity test chamber, as the core equipment of the laboratory, plays an irreplaceable role in agricultural pesticide research and development, production and application.

Experiment box technology promotes the development of humanoid robots, and has broad application prospects in the future
In recent years, humanoid robot technology has developed rapidly around the world and has become an important research direction in the field of artificial intelligence and robotics. In this process, the test chamber, as a key technology verification and development platform, has played an important role in promoting the research and development of humanoid robots.
Daily cleaning and maintenance of mold test chamber
Mold test chamber is used to test the mold resistance and microbial resistance of various electronic instruments, materials, parts and equipment under different temperature and humidity conditions. As a precision instrument, the mold test chamber needs to be cleaned and maintained regularly.

The new energy vehicle wave is surging, and the automotive environmental test chamber helps the industry take off
In recent years, with the enhancement of global environmental awareness and the advancement of the "dual carbon" goals, the new energy vehicle industry has ushered in explosive growth. As an important link in the automotive industry chain, automotive environmental Test Chambers have also ushered in new development opportunities.

Rain Test Chamber: A Competition Between Rain and Technology
The rain test chamber is an artificial simulation equipment used to simulate the natural rainfall environment. Below we introduce it in detail.

What is a constant temperature and humidity test chamber?
Constant temperature and humidity test chamber can detect parameters and performance after high temperature, low temperature, alternating humidity and heat or constant test temperature environment changes.

Thermal Shock Test Chamber: How To Choose And Installation Requirements
The thermal shock test chamber, also known as the "high and low temperature shock test chamber" or "temperature shock test chamber", is a common environmental testing equipment in laboratories and production units. It is used in the metal, plastic, rubber, electronics and other industries to test the degree to which materials can withstand continuous extremely high and low temperatures in an instant, so as to detect chemical changes or physical damage caused by thermal expansion and contraction of the sample in the shortest time. Let's see how to choose it and what are the requirements for installation?

About Three box-type Thermal Shock Test Chamber
In the process of product development and quality control, simulating product performance under extreme environmental conditions is a crucial task. Thermal shock test is a common method used to evaluate the performance stability of materials or products under rapid temperature changes. As an advanced testing equipment, the Three box-type Thermal Shock Test Chamber has been widely used in aerospace, electronics, automobile manufacturing and other industries.

How to select a drug stability test chamber
Drug stability test chambers are widely used in pharmaceutical and other scientific research institutions for drug stability test operations. They are usually composed of a chamber, a refrigeration system, etc. There are many brands and models of drug stability test chambers on the market. To choose a suitable drug stability test chamber, you need to master some key points for selecting drug stability test chambers. Next, let me show you the common selection methods:












